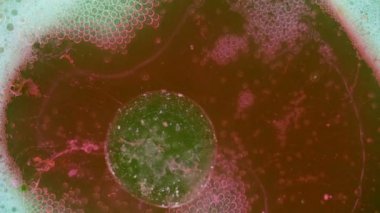
Boya yapmamı. Harika desenler

İhlal Bildirim Formu
En Çok Aranan Kelimeler
toplaryeşilRenkMavivektörArkaplanRenklimakrodizaynİzole edilmişşekilGüzelsanatıslakSıvıSoyutdokuSu.TuruncupetrolDesendoymuşsiyahGrungesuluboyamürekkepboyaSıçralambaAsitdamlacıkDuvar Kağıdıçok renkliKabarcıklarsanatsalBilimaltındaTuhaf.MotleyvaricoloredPsikedelikbalonlarHavai fişekMikroskopMoleküllavkimyasal reaksiyonBenzer İçerikler